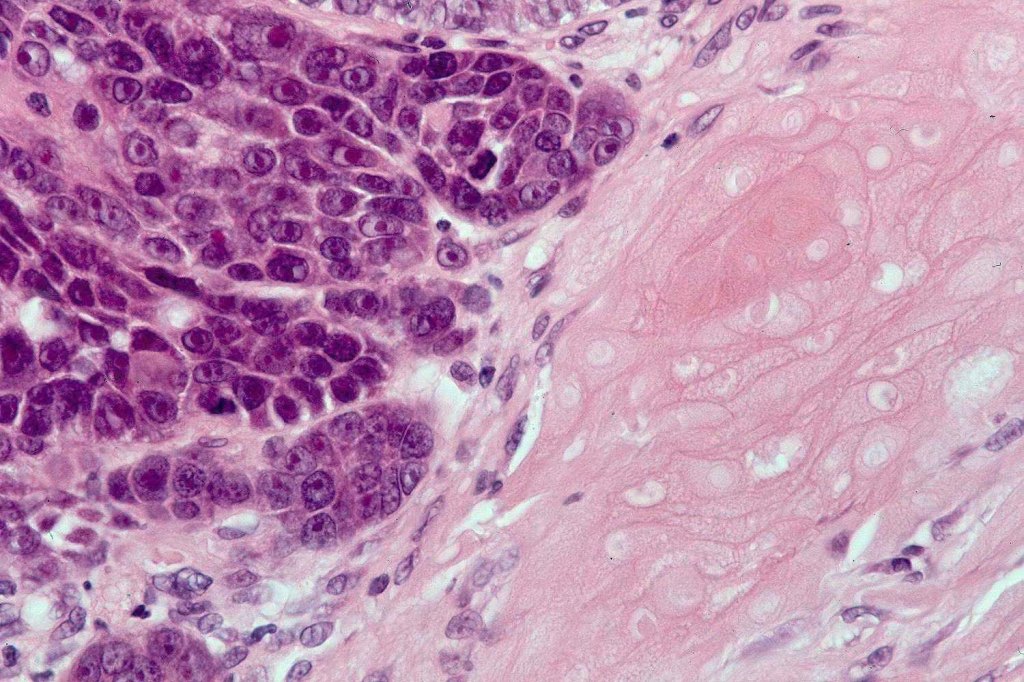
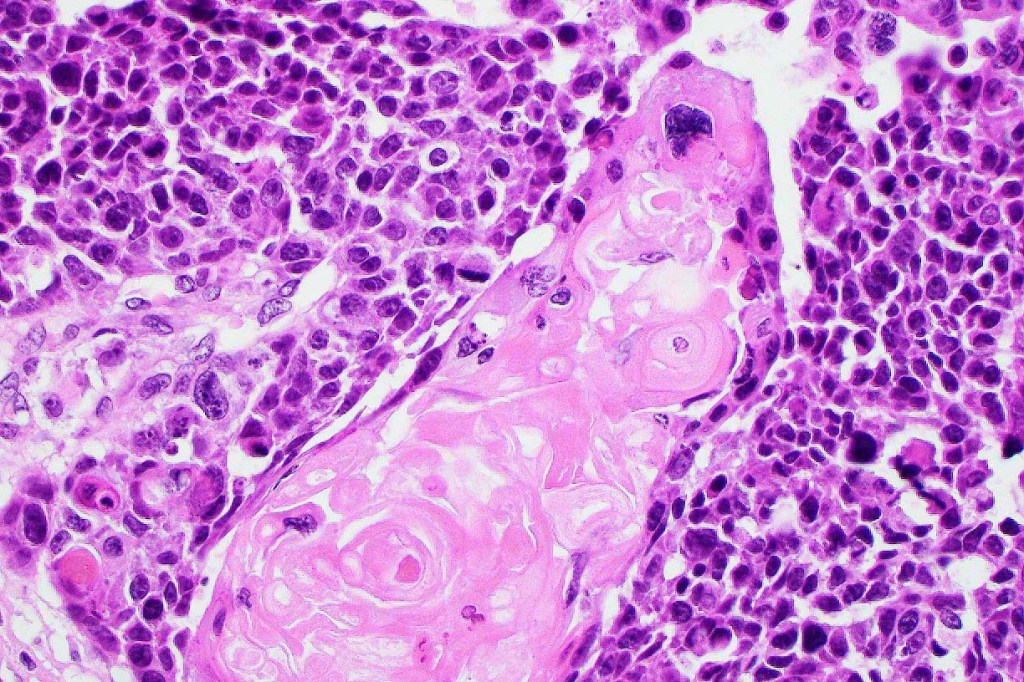
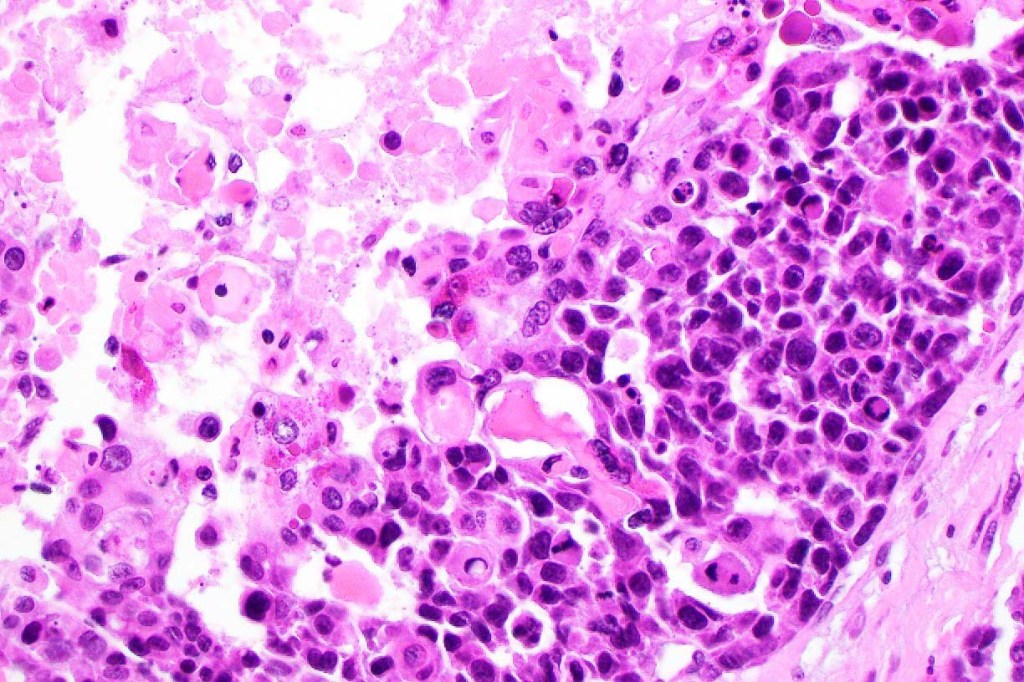

Clinical features
•4M:1F
•O.5-20 cm (mean 4.0 cm) firm/hard slowly growing nodule or plaque
•Scalp, posterior neck, post-auricular region & upper back
•Sometimes pigmented
•Best regarded as a high-grade tumor with significant recurrence rate and risk of systemic spread. In the past it was regarded as a low-grade tumor but this is because many pilomatricomas were misdiagnosed as being malignant based on the mitotic activity
Histological features
•Lobular or a diffusely infiltrating growth pattern. Composed of pleomorphic hyperchromatic, basaloid cells with nucleolar prominence, abundant mitoses & atypical mitoses (brisk mitotic activity should not be used as a defining feature of matrical carcinoma since in the evolving phase mitoses are typically very numerous in pilomatricoma)
•Necrosis common
•Matricial & supramatricial differentiation
•Clear cell change
•Squamous differentiation
•Melanocytic colonization (pigmented matrical carcinoma. This should not be confused with melanocytic matricoma (see differential diagnosis)
•Sarcomatoid variant (matricial carcinosarcoma, metaplastic carcinoma)
•The basaloid cells show strong nuclear & cytoplasmic expression of beta catenin

Differential diagnosis
•Mitotic activity is typically present in pilomatricoma, and this should not be used as a basis for diagnosing carcinoma
•Melanocytic matricoma (and its so-called malignant counterpart) is a rare biphasic tumor composed of sharply demarcated lobules comprising matricial elements and dendritic melanocytes and which arises on the sun-damaged skin of the elderly. It can be confused with and to some extent overlaps matrical carcinoma. Points of distinction include small size (< 1cm), absence of atypical mitoses, necrosis, lymphovascular invasion & perineural infiltration. The malignant variant may show an infiltrating border. Caution is advised when making this diagnosis to exclude pigmented matricoma and malignant matricoma. This entity will be covered in a separate bog.
•Proliferating pilomatricoma (a rare variant seen in the elderly) is characterized by basaloid cell pleomorphism, nuclear hyperchromatism and marked mitotic activity including atypical forms. The tumor is small (0.2-1.7 mm), generally presents as a papule or small nodule and does not show necrosis. Lymphovascular invasion & perineural infiltration are not seen. Diagnosis should be made with caution since it very much overlaps with matrical carcinoma
•Pigmented basal cell carcinoma may be distinguished by the presence of peripheral palisading, retraction artifact and mucin deposition
If you enjoy this blog, please subscribe and hit the like button. This is very important to me. These blogs are not static or cast in stone. If you have relevant comments, these can be added (see comment box at end of blog). Similarly, if you have additional cases that you would like to contribute, please email me on phmckee1948@gmail.com. Please note that only well-stained, perfectly focused and high resolution images can be considered.
Leave a comment